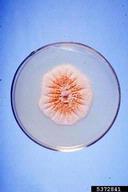

Florida Division of Plant Industry , Florida Department of Agriculture and Consumer Services, Bugwood.org
Kutilakesa fungus (Kutilakesa pironii) symptoms on ceniza (Leucophyllum frutescens)

Florida Division of Plant Industry , Florida Department of Agriculture and Consumer Services, Bugwood.org
Kutilakesa fungus (Kutilakesa pironii) symptoms on paperplant (Fatsia japonica)

Florida Division of Plant Industry , Florida Department of Agriculture and Consumer Services, Bugwood.org
Kutilakesa fungus (Kutilakesa pironii) symptoms on ceniza (Leucophyllum frutescens)
Florida Division of Plant Industry , Florida Department of Agriculture and Consumer Services, Bugwood.org
PDA 19 day old cultures. Isolated from edible fig {Ficus carica).